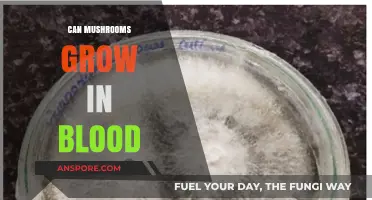
Can Mushrooms Thrive in Blood? Unraveling the Myth and Science

The question of whether mushrooms can grow in a jar that is not completely colonized by mycelium is a common concern among cultivators. Colonization refers to the process where mycelium, the vegetative part of a fungus, spreads throughout the substrate in a jar. While full colonization is ideal for maximizing yield and ensuring healthy mushroom growth, partial colonization does not necessarily mean failure. Mushrooms can still grow if the mycelium has sufficiently established itself, though the harvest may be smaller or less consistent. Factors such as the type of mushroom, substrate quality, and environmental conditions play a crucial role in determining the success of partial colonization. Understanding these dynamics can help cultivators make informed decisions about when to proceed with fruiting or whether to wait for further colonization.
| Characteristics | Values |
|---|---|
| Complete Colonization Required | Not strictly necessary for mushroom growth, but optimal colonization increases yield and success rate. |
| Minimum Colonization Needed | At least 70-80% colonization is recommended for most mushroom species to ensure healthy fruiting. |
| Risk of Contamination | Higher risk if colonization is incomplete, as uncolonized areas can be vulnerable to mold or bacteria. |
| Fruiting Potential | Mushrooms can still fruit from partially colonized jars, but the yield will likely be lower and less consistent. |
| Species Variability | Some mushroom species (e.g., oyster mushrooms) are more forgiving and can fruit with less colonization compared to others (e.g., shiitake). |
| Time to Fruiting | Partially colonized jars may take longer to initiate fruiting due to weaker mycelium networks. |
| Quality of Mushrooms | Mushrooms from partially colonized jars may be smaller, less robust, or have abnormal growth patterns. |
| Best Practice | Always aim for complete colonization to maximize success, yield, and mushroom quality. |
| Salvaging Partially Colonized Jars | Possible by transferring the colonized substrate to a bulk grow environment or using it as spawn for another grow. |
| Environmental Factors | Proper humidity, temperature, and light conditions can still trigger fruiting in partially colonized jars, but results are less predictable. |
Explore related products
$14.99
What You'll Learn
- Partial Colonization Success: Can mushrooms fruit if mycelium hasn’t fully colonized the jar substrate
- Contamination Risks: Does incomplete colonization increase chances of mold or bacterial growth
- Fruiting Potential: Will mushrooms still grow if colonization is slow or stalled
- Optimal Conditions: How do temperature, humidity, and light affect partial colonization outcomes
- Rescue Techniques: Can partially colonized jars be saved for successful mushroom growth

Partial Colonization Success: Can mushrooms fruit if mycelium hasn’t fully colonized the jar substrate?
Mushrooms can indeed fruit even if the mycelium hasn’t fully colonized the jar substrate, but success depends on several factors. Partial colonization often occurs when the mycelium has spread through 70–90% of the substrate, leaving small uncolonized patches. In such cases, the mycelium may still have sufficient resources to initiate fruiting, especially if the colonized areas are dense and healthy. However, the yield will likely be lower compared to a fully colonized jar, as the mycelium’s energy is divided between further colonization and fruiting. Observing the jar for signs of pinning (tiny mushroom primordia) can indicate whether the mycelium is ready to fruit despite incomplete colonization.
To encourage fruiting in partially colonized jars, focus on creating optimal fruiting conditions. Introduce a humid environment with 90–95% humidity, maintain temperatures between 65–75°F (18–24°C), and provide indirect light. Light exposure is crucial for triggering fruiting, as mushrooms use photoreceptors to sense when to develop primordia. Additionally, ensure proper gas exchange by using a breathable lid or opening the jar slightly. If the substrate appears dry, lightly mist the surface, but avoid overwatering, as excess moisture can lead to contamination. Patience is key, as partially colonized jars may take longer to fruit.
Comparing fully colonized and partially colonized jars highlights the trade-offs. Fully colonized jars typically produce larger, more consistent flushes because the mycelium has maximized nutrient absorption. Partially colonized jars, however, can still yield mushrooms, though the harvest may be smaller and less uniform. For hobbyists, this can be an opportunity to salvage a grow that hasn’t progressed as expected. Commercial growers, on the other hand, may prioritize fully colonized substrates for efficiency and predictability. Understanding these differences helps in deciding whether to proceed with fruiting or wait for further colonization.
A practical tip for dealing with partial colonization is to monitor the jar’s progress closely. If the mycelium hasn’t advanced after 2–3 weeks in fruiting conditions, it may indicate insufficient colonization or contamination. In such cases, consider transferring the colonized substrate to a new jar with fresh substrate to boost colonization. Alternatively, if pinning occurs, focus on maintaining fruiting conditions to support mushroom development. Documenting each grow cycle, including colonization rates and fruiting outcomes, can provide valuable insights for improving future attempts. Partial colonization isn’t a failure—it’s a learning opportunity to refine techniques and maximize yields.

Contamination Risks: Does incomplete colonization increase chances of mold or bacterial growth?
Incomplete colonization in mushroom cultivation jars creates pockets of unoccupied substrate, which become breeding grounds for contaminants. When mycelium fails to fully colonize, nutrients remain available for competing organisms like mold and bacteria. These invaders thrive in the same conditions mushrooms require—moisture, organic matter, and warmth—but outcompete slow-growing mycelium in under-colonized areas. For instance, a jar with only 70% colonization provides ample space for *Aspergillus* mold or *Bacillus* bacteria to establish, especially if sterilization was imperfect or environmental controls (like humidity or temperature) fluctuated.
Analyzing the risk factors reveals a compounding effect. Incomplete colonization often results from suboptimal conditions during incubation, such as inadequate sterilization, improper substrate hydration (e.g., 60-70% moisture content instead of 55-60%), or temperature deviations (below 75°F or above 80°F). These same issues weaken the mycelium’s competitive edge, allowing contaminants to exploit vulnerabilities. For example, a study on *Pleurotus ostreatus* showed that jars with less than 80% colonization had a 40% higher contamination rate compared to fully colonized jars under identical conditions.
To mitigate risks, cultivators must adopt precise practices. First, ensure substrate sterilization reaches 250°F for at least 30 minutes to eliminate spores. Second, maintain incubation temperatures between 75-80°F and humidity at 60-70% to favor mycelial growth over contaminants. If colonization stalls, inspect for signs of mold (fuzzy textures, green/black spots) or bacterial slime (yellow/brown, wet patches). Contaminated jars should be isolated immediately to prevent spore spread. For partially colonized jars, consider transferring healthy mycelium to a fresh, sterilized substrate, discarding the compromised portion.
Comparing fully colonized and partially colonized jars highlights the importance of patience. Rushing the process by transferring to fruiting conditions prematurely increases contamination risk. Fully colonized jars (100% white, dense mycelium) create a protective barrier against invaders, while incomplete colonization leaves gaps. For example, *Lentinula edodes* (shiitake) mycelium takes 4-6 weeks to fully colonize under optimal conditions; attempting fruiting at 3 weeks significantly raises mold risk. Cultivators should prioritize thorough colonization over speed, as the payoff in yield and contamination prevention is substantial.
In conclusion, incomplete colonization is not merely an aesthetic issue but a critical risk factor for mold and bacterial growth. By understanding the interplay between mycelial competition, environmental conditions, and contamination vectors, cultivators can implement targeted strategies to safeguard their crops. Patience, precision, and proactive monitoring are the cornerstones of minimizing risks and maximizing success in mushroom cultivation.

Fruiting Potential: Will mushrooms still grow if colonization is slow or stalled?
Mushrooms are resilient organisms, but their fruiting potential hinges on successful colonization of the substrate. If colonization is slow or stalled, fruiting may still occur, but the outcome depends on several factors. Slow colonization often results from suboptimal conditions, such as improper temperature, humidity, or contamination. However, if the mycelium is healthy and the stall is temporary, it can recover and produce mushrooms, though yields may be reduced.
Analyzing the situation requires patience and observation. A stalled jar doesn’t always mean failure. For instance, if the mycelium has colonized 70–80% of the substrate, it may still have enough strength to fruit, especially if conditions improve. Key indicators include the absence of mold, a healthy white mycelium, and no foul odors. If these conditions are met, transferring the partially colonized substrate to a fruiting chamber can sometimes trigger pinhead formation, though results vary by mushroom species.
To maximize fruiting potential in partially colonized jars, take proactive steps. First, ensure the environment is ideal: maintain temperatures between 65–75°F (18–24°C) and humidity above 90%. Introduce fresh air exchange by opening the jar for 1–2 minutes daily to prevent CO2 buildup. If contamination is minimal, carefully remove affected areas with a sterilized tool. For stalled but healthy mycelium, shock the substrate by placing it in a fridge at 40°F (4°C) for 24 hours, then return it to fruiting conditions to stimulate growth.
Comparing species reveals differing resilience. Oyster mushrooms (Pleurotus ostreatus) are more forgiving and can fruit from partially colonized substrates, while gourmet varieties like lion’s mane (Hericium erinaceus) require near-complete colonization for optimal yields. Beginners should start with resilient strains and monitor progress closely. Even if fruiting is sparse, the experience provides valuable insights for future grows, turning a potential setback into a learning opportunity.
In conclusion, while slow or stalled colonization doesn’t guarantee failure, it demands attention and adjustment. By understanding the mycelium’s health, optimizing conditions, and tailoring approaches to specific species, growers can still coax mushrooms into fruiting. Patience and adaptability are key—sometimes, the most challenging grows yield the most rewarding harvests.
Explore related products

Optimal Conditions: How do temperature, humidity, and light affect partial colonization outcomes?
Partial colonization in mushroom cultivation often leaves growers wondering if their efforts will yield fruit. While a fully colonized substrate is ideal, understanding the interplay of temperature, humidity, and light can salvage partially colonized jars. These factors don’t just influence growth—they determine whether your mycelium thrives or stalls.
Temperature acts as the catalyst for mycelial activity. Most mushroom species prefer a range of 70–75°F (21–24°C) during colonization. Deviations below 65°F (18°C) slow metabolic processes, while temperatures above 80°F (27°C) can stress or kill the mycelium. For partially colonized jars, maintaining the upper end of this range (75°F) can accelerate growth, but monitor closely to avoid overheating. Pro tip: Use a heating pad with a thermostat to stabilize temperatures, especially in cooler environments.
Humidity is equally critical, though often misunderstood. While high humidity (90–95%) is essential during fruiting, colonization requires a balance. Excess moisture in partially colonized jars can lead to contamination, as competing molds thrive in damp conditions. Aim for 70–80% humidity during colonization, ensuring the substrate remains moist but not waterlogged. Misting the jar’s surface sparingly or using a humidifier with a hygrometer can help maintain this delicate equilibrium.
Light’s role in colonization is subtle yet significant. Unlike fruiting bodies, mycelium doesn’t require light to grow, but indirect exposure can stimulate activity. Place partially colonized jars near a window with filtered sunlight or use a low-intensity LED grow light for 4–6 hours daily. Avoid direct sunlight, as it can overheat the substrate. This gentle nudge can encourage mycelium to spread, bridging gaps in partial colonization.
Finally, patience is your greatest tool. Partially colonized jars may take 2–4 weeks longer to reach full colonization. Resist the urge to intervene excessively—over-misting, frequent opening, or drastic temperature changes can introduce contaminants. Instead, create a stable environment and let the mycelium work. If contamination appears, isolate the jar immediately to protect other cultures.
By fine-tuning temperature, humidity, and light, growers can coax partial colonization into success. While not every jar will recover, understanding these optimal conditions maximizes the chances of a fruitful harvest.

Rescue Techniques: Can partially colonized jars be saved for successful mushroom growth?
Partially colonized jars often leave cultivators wondering whether their efforts are salvageable. The mycelium’s slow or uneven spread can signal contamination, insufficient nutrients, or environmental stress. However, not all is lost. Rescue techniques exist to revive these jars, provided the issue is addressed promptly and correctly. The key lies in identifying the root cause—whether it’s improper sterilization, inadequate moisture, or temperature fluctuations—and taking targeted corrective action.
One effective rescue method involves transferring the partially colonized substrate to a new, sterile jar. Begin by sterilizing fresh substrate and allowing it to cool. Carefully remove the healthy mycelium from the original jar, avoiding contaminated areas, and introduce it to the new container. Maintain optimal conditions—70-75°F (21-24°C) and high humidity—to encourage rapid colonization. This technique, known as "re-jarrying," can save up to 70% of the culture if contamination is minimal and caught early.
Another approach is to introduce beneficial bacteria or trichoderma, a fungus that competes with contaminants. Mix 1 teaspoon of trichoderma inoculant per 5 pounds of substrate, ensuring even distribution. This biological control can suppress harmful microbes while allowing the mycelium to thrive. However, this method is best suited for experienced growers, as improper application may exacerbate issues. Always monitor the jar closely for 7-10 days post-treatment.
For jars with slow colonization due to nutrient deficiency, supplementing the substrate with organic additives like worm castings or alfalfa meal can rejuvenate growth. Mix 10-15% by volume into the substrate, ensuring thorough incorporation. This boosts available nutrients, accelerating mycelial expansion. Pair this with increased humidity—mist the jar lightly or use a humidifier—to create an ideal environment for recovery.
While rescue techniques offer hope, prevention remains paramount. Always sterilize jars at 250°F (121°C) for 30-45 minutes, use high-quality substrate, and maintain sterile practices during inoculation. For beginners, starting with resilient strains like oyster mushrooms increases success rates. With patience and precision, partially colonized jars can still yield fruitful harvests, transforming potential failures into learning opportunities.
Frequently asked questions
Mushrooms can still grow if the jar is not completely colonized, but the yield will likely be lower, and the risk of contamination increases.
If the jar is only partially colonized, the mycelium may not have enough strength to produce a robust fruiting body, resulting in smaller or fewer mushrooms.
Transferring a partially colonized jar to a fruiting chamber is possible, but it’s riskier because uncolonized areas can become breeding grounds for contaminants.
To encourage growth, ensure optimal fruiting conditions (humidity, light, and temperature) and give the jar more time to colonize before initiating fruiting.
If the jar isn’t fully colonized after 4-6 weeks and shows no signs of further growth, it’s best to discard it to avoid contamination spreading to other jars.